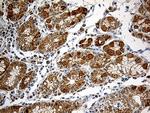
CHCHD10 Antibody in Immunohistochemistry (Paraffin) (IHC (P))

Search
图: 1 / 15
CHCHD10 Antibody (MA5-27531) in ICC/IF

Please note: We are reviewing Western blot images included in the antibody testing data in our catalog, including those provided by third parties. Unless expressly labeled or annotated as “raw-unedited”, Western blot images included in the antibody testing data in our catalog may have been edited, optimized or otherwise adjusted for presentation.
产品信息
MA5-27531
种属反应
已发表种属
宿主/亚型
分类
类型
克隆号
抗原
偶联物
形式
浓度
规格
纯化类型
保存液
内含物
保存条件
运输条件
RRID
靶标信息
CHCHD10 encodes a mitochondrial protein that is enriched at cristae junctions in the intermembrane space. It may play a role in cristae morphology maintenance or oxidative phosphorylation. Mutations in this gene cause frontotemporal dementia and/or amyotrophic lateral sclerosis-2. Alternative splicing of this gene results in multiple transcript variants. Related pseudogenes have been identified on chromosomes 7 and 19.
仅用于科研。不用于诊断过程。未经明确授权不得转售。
生物信息学
蛋白别名: Coiled-coil-helix-coiled-coil-helix domain-containing protein 10, mitochondrial; Protein N27C7-4
基因别名: C22orf16; CHCHD10
Entrez Gene ID: (Human) 400916




